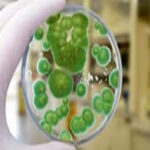
ALL US Mold Removal & Remediation - Frisco TX-Frisco

Best Mold Removal Services Near Frisco, Tx
📞+1-833-331-2789
Welcome to Frisco, Texas, a vibrant city that perfectly blends modern living with a rich sense of community. Nestled in the heart of the Dallas-Fort Worth Metroplex, Frisco has rapidly evolved into one of the most sought-after destinations in the region. With its booming economy, top-notch schools, and a plethora of recreational opportunities, it’s no wonder that both families and young professionals are flocking to this dynamic city. Whether you’re a sports enthusiast, a foodie, or someone who enjoys the outdoors, Frisco has something to offer everyone.
As you explore the diverse attractions and activities that Frisco has to offer, you’ll discover why this city has captured the hearts of so many. From its world-class shopping and dining experiences to its rich cultural offerings and beautiful parks, Frisco is a place where adventure and relaxation coexist. Get ready to embark on a journey through the highlights of this remarkable city, and find out why Frisco is not just a place to live, but a community to thrive in.
Top Businesses Offering Emergency Mold Removal & Cleanup in Frisco, Texas
7 results
- 4.9 (332)
-
-
Easy Breezy Cleaning Company is a premier cleaning service dedicated to providing top-notch cleaning solutions for both residential and commercial spaces. With a commitment to e…
-
Julius Frago
I recently used Easy Breezy Cleaning Co., and I couldn't be happier with the experience! Nancy and her team were professional, efficient, and thorough in their work. They left my home spotless and paid attention to every detail, ensuring nothing was overlooked. The booking process was seamless, and their communication throughout was excellent. I highly recommend Easy Breezy Cleaning Co. to anyone looking for reliable and high-quality cleaning services. Thank you for making my life a little easier!
Read more -
Carole Evans
I’ve been using Easy Breezy for quite awhile now. They do a thorough job. Theresa is always on time and reliable. I’m considering doing a spring cleaning next!
Read more -
Rosa Baker
I hired Dallas Sunrise Maids to clean our new home before we moved in. I was pleased to see all of the 5-star reviews. When I booked the appointment I informed them that the house had already been cleaned but some areas were not done well, specifically inside the cabinets and drawers. They told me they would clean everything including inside the cabinets and drawers. A two-person crew arrived. They spoke little to no English which was different than what I was told. However, when they were finished I proceeded to try and review what they cleaned. They appeared annoyed with me doing so and assured me that they cleaned inside cabinets, etc. I paid them in cash with a tip. They didn't even say thank you. After they left, I proceeded to open all drawers and cabinets all over the house. It was very clear at that point that they DID NOT clean inside all cabinets and drawers. I called Dallas Sunrise Maids to tell them about the service. They asked ME questions like "how long do you think it would take them to clean the cabinets?" How should I know?! You're the professional cleaners, not me! His line of questioning was just to box me into how much a refund I should get. Dallas Sunrise Maids provided me with a $25 credit. I guess that's reimbursement for MY time to clean all of the cabinets and drawers in a 3000+ sq ft house. I do not recommend this company. creat 100 word short content
Read more
- 9355 John W. Elliott Dr #25535, Frisco, TX 75033, United States
- NA (NA)
-
-
ALL US Mold Removal & Remediation, located in Frisco, TX, is a premier service provider specializing in comprehensive mold inspection, removal, and remediation solutions. O…
-
Noah
I recently had a wonderful experience at ALL US Mold Removal & Remediation in Frisco, TX. The staff was friendly and professional, making the entire process smooth and hassle-free. Their attention to detail and commitment to quality service truly stood out. I highly recommend them for anyone in need of mold removal services!
Read more -
Rhiannon
I recently had a great experience at ALL US Mold Removal & Remediation in Frisco, TX. The staff was friendly and professional, making the process smooth and stress-free. Their attention to detail and commitment to quality really stood out. I highly recommend them for anyone in need of mold removal services!
Read more -
Bethany
I recently had a fantastic experience at ALL US Mold Removal & Remediation in Frisco, TX. The staff was friendly and knowledgeable, making the process smooth and stress-free. The service was efficient, and I felt well taken care of throughout. Highly recommended for anyone in need of mold removal services!
Read more
- 1701 Legacy Dr, Frisco, TX 75034, United States
- 5 (25)
-
-
Veteran Restoration is a dedicated service provider specializing in restoring residential and commercial properties affected by water, fire, mold, and storm damage. Founded by a…
-
Susana Crawford
Veteran Restoration does what it takes to provide exceptional and responsive service! After returning from a weekend trip, I had a leak from my second floor to my downstairs. Even though it was late on a Sunday evening, Steven was quick to respond and extremely patient even though I was distraught (freaking out). He gave me all my options, explained the entire process for filing an insurance claim then kept me updated on the progress for repairs. The area was kept clean during and after the dry out and repair. This is the company you want to call for any water damage or fire restoration needs!
Read more -
Kevin Stone
When our home flooded, Veteran Restoration was there within a few hours and worked tirelessly for over a week to dry our home out. They found all the wet areas through their careful demolition, then made sure it was all dry. They were excellent to work with, always on time and professional. We strongly recommend Veteran Restoration
Read more -
Thomas Weldon
Veterans Restoration came to our rescue after Hurricane Ian in Fort Myers, Florida. We were at a loss about what to do. When we met the owner of Veteran we were immediately comfortable with the company and their plans to dry our house. It was a big job- lots of water. Within 3 days after job commencement they were putting in the fans for drying. We now have a dry house and can commence reconstruction. The entire Veteran team of 10+ worked together to save what we could and carried out what we couldn’t save all while doing the prep for drying. The technology they use and their ability to work with insurance company was amazing and put our minds at ease. They even provided assistance to the contractor for the rebuild and worked with the insurance adjuster. Thanks to all on the Veteran team.
Read more
- 124 Rose Ln 604 Building 5, Frisco, TX 75034, United States
- 5 (14)
-
-
DRYmedic of Plano is a premier restoration and remediation company dedicated to providing top-notch services for both residential and commercial clients. Specializing in water d…
-
Phil Forti
These guys were amazing!! This was an incredibly hard time for our family and they made it way more manageable.We had a water leak a at the end of October and we were back in our home 2 weeks before Christmas. They handled everything from the drying all the way to reconstruction. I hope i never have to do this again but if I do i know that I will be in good hands. The greatest thing about the entire experience is the level of respect they had for my home and how well they treated my dogs. At times I felt my dog charlie liked Leo more than me. Thank you so much for taking such great care of my home and my family. Would recommend this great group of guys to anyone that is in need of this service.
Read more -
Luis Castillo Baron
⭐⭐⭐⭐⭐ I recently had the pleasure of working with DRYmedic of Plano after a significant water damage event in my home. From start to finish, their team was professional, efficient, and incredibly supportive. The initial assessment was thorough, and they explained every step of the process in detail, making sure I understood what needed to be done and why. The technicians were punctual and worked diligently to mitigate the damage, always respecting my property and personal space. What truly stood out was their attention to detail and commitment to ensuring everything was done right. They used state-of-the-art equipment and techniques, which gave me confidence that my home was in good hands. Throughout the process, they kept me informed and answered all my questions promptly. Thanks to DRYmedic a Mr Leo, my home is now fully restored, and I couldn't be happier with the results. I highly recommend their services to anyone in need of mitigation work. They turned a stressful situation into a manageable one, and for that, I am incredibly grateful.
Read more -
Jesus Baron
The team arrived promptly and quickly assessed the extent of the damage. They explained the process clearly and were very thorough in their work. They used advanced equipment to dry out the affected areas and prevent mold growth, which gave me peace of mind. Throughout the restoration process, they kept me updated on their progress and were always available to answer any questions I had. The technicians were courteous and respectful of my property, ensuring minimal disruption to my daily routine.
Read more
- 6950 Eubanks St B-8, Frisco, TX 75034, United States
- 4.9 (174)
-
-
PuroClean Restoration Specialists is a leading provider of property damage restoration services, dedicated to helping homeowners and businesses recover from disasters. With a co…
-
Elaine M
These guys at puroclean are life savers!! I've unluckily had 2 flood emergencies and water damage in my home over the past year and a half and called puroclean who came highly recommended to me by a friend. I was able to get through to someone immediately for help and I felt like I was in great hands with a very competent crew and they helped me right away with clean up and mold prevention. Also very reasonably priced so I didn't feel like I was breaking the bank considering their high quality and swift services. 10/10 would recommend them for any home restoration emergencies!
Read more -
Caree Rahberg
PuroClean literally came to our rescue after our house flooded. Terrin visited our house multiple times to assess and address the damage in our home. Each time, he was thorough, efficient and polite. We appreciated his compassion and courtesy very much. We highly recommend him and PuroClean when a restoration specialist is needed for your home or business.
Read more -
Dr. B Hanson
My husband and I were very pleased with the Restoration Services provided by PuroClean’s McKinney.Frisco office. Our technician, Nick, was an amazing young man who patiently answered all of our questions, was knowledgeable and professional in the performance of his work, and was empathetic regarding the mess our house was in from the water intrusion. We were completely comfortable having him work in our home. Thanks Nick!
Read more
- 122 Rose Ln Suite 103, Frisco, TX 75036, United States
- 5 (20)
-
-
Water Damage Restoration Frisco is a premier service provider dedicated to restoring homes and businesses affected by water-related disasters. Our expert team specializes in rap…
-
Shaquon Harris
Great company to work with. We had a flood in our home and called them after hours. They responded to our house very fast. Excellent job with the water restoration process.
Read more -
M Trevino
I am very Very happy with this water restoration company! I called them after our kitchen flooded and they did a remarkable job fixing it! Excellent job!
Read more -
Jeremy W. Carroll
What a world class company!! Great customer service, I was dealing with water damage for a failed water line… Water damage restoration gave me the red carpet treatment as the repair begun walking me thru the process step by step communicating where we were at in the project the entire way!! 10 out of 10 would recommend, great work!!!
Read more
- 6136 Frisco Square Blvd, Frisco, TX 75034, United States
- 4.9 (317)
-
-
Dry Force Water Removal Specialists is a premier service provider dedicated to restoring properties affected by water damage. With a commitment to excellence and customer satisf…
-
Bre Williams
Michael and John came right out and right in and started working on my issue! From the operator who took the call to the exceptional customer service that Micheal and John has shown, I highly recommend Dry Force! Michael assured me that everyone coming after him will continue to give their BEST to restore my home. I don’t hope to need you again but if I do, I have you on speed dial now! Thank you!
Read more -
Koni Richardson
Michael Wilson with DryForce was truly a godsend. He arrived promptly, assessed the damage thoroughly, and clearly explained each step of the restoration process. He also went above and beyond by assisting me with filing a homeowners insurance claim. I truly appreciate his patience, professionalism, and expertise throughout the entire experience
Read more -
Edie Zilio
Michael Wilson was exceptional. Very nice, friendly and professional. Walked us through the entire process, explained every step that’s going to happen and was very patient answering all our questions. Highly recommend working with Michael.
Read more
- 7460 Warren Pkwy #161, Frisco, TX 75034, United States
No results available
ResetAs we wrap up our exploration of Frisco, Texas, it’s clear that this vibrant city is more than just a place to live; it’s a thriving community filled with opportunities for fun, growth, and connection. From the bustling shopping centers and diverse dining options to the serene parks and engaging cultural attractions, Frisco offers a little something for everyone. Whether you’re a sports enthusiast cheering on the local teams or a family looking for enriching activities, you’ll find Frisco’s charm hard to resist.
The city’s commitment to innovation and community development ensures that it will continue to be a desirable destination for years to come. With its welcoming atmosphere and a strong sense of community, Frisco exemplifies the best of Texas living. So whether you’re planning a visit or considering a move, Frisco is undoubtedly worth your attention. Embrace all that this remarkable city has to offer, and you may just discover your new favorite place to call home.
Common causes for Mold Removal in Frisco
– High Humidity Levels
– Water Leaks from Plumbing
– Roof Leaks and Poor Insulation
– Flooding and Water Damage
– Condensation on Windows and Walls
– Improper Ventilation in Bathrooms and Kitchens
– Damp Basements and Crawl Spaces
– Flooding from Heavy Rainfall or Storms
Mold Damage Restoration & Emergency Mold Services Offered in Frisco
– Comprehensive Mold Inspection and Assessment
– Safe Mold Remediation Techniques
– Advanced Air Quality Testing
– Thorough Surface Cleaning and Disinfection
– Water Damage Restoration Services
– Mold Prevention and Maintenance Solutions
– Expert Consultation and Guidance
– 24/7 Emergency Mold Removal Services
Tips for Choosing a Mold Removal & Remediation Service in Frisco
– Verify Licensing And Insurance Credentials
– Check Customer Reviews And Testimonials
– Inquire About Their Experience And Expertise
– Assess Their Response Time And Availability
– Confirm The Use Of Advanced Equipment And Techniques
– Request A Detailed Written Estimate
– Ensure They Provide Comprehensive Services
– Ask About Their Warranty And Follow-Up Procedures
FAQs About Mold Remediation & Cleanup in Frisco
How Much Does mold removal in Frisco Typically Cost?
The cost of mold removal in Frisco typically ranges from $500 to $3,000, depending on various factors such as the extent of the mold infestation, the area affected, and the methods used for removal. Small, contained areas may cost around $500 to $1,500, while larger infestations or complex situations can exceed $2,000. Additional costs may arise if repairs are needed or if mold testing is conducted beforehand. It’s advisable to obtain quotes from multiple professionals to ensure a fair estimate based on your specific situation.
How long does the mold remediation process take in Frisco?
The mold remediation process in Frisco typically takes anywhere from 1 to 7 days, depending on several factors. These factors include the extent of the mold growth, the size of the affected area, and the complexity of the remediation needed. For minor infestations, the process may be completed within a day or two, while more extensive issues could require a week or more. Additionally, drying and repairing any water damage can add to the timeline. It’s important to conduct a thorough assessment and follow proper procedures to ensure all mold is effectively removed and does not return.
How quickly can I get mold removal services in Frisco?
The speed at which you can get mold removal services in Frisco depends on several factors, including the availability of local service providers and the severity of the mold issue. Typically, many companies offer same-day or next-day assessments. Once an inspection is completed, the actual removal process can take anywhere from a few hours to several days, depending on the extent of the mold growth. To expedite the process, it’s advisable to contact multiple mold removal services in your area and inquire about their availability. Emergency services may also be available for urgent situations.
Should I hire a professional for mold removal in Frisco, or can I do it myself???
Hiring a professional for mold removal in Frisco is often the best choice, especially for extensive infestations or if you have health concerns. Professionals have the necessary training, equipment, and safety gear to effectively remove mold and prevent its return. They can also identify hidden moisture sources that may not be apparent. DIY methods may work for small, surface mold issues, but improper handling can lead to further contamination and health risks. If you choose to do it yourself, ensure you follow safety guidelines, use appropriate protective gear, and properly ventilate the area. Ultimately, for peace of mind and thoroughness, hiring a professional is recommended.
Do mold removal companies in Frisco offer emergency services?
Yes, many mold removal companies in Frisco offer emergency services. These services are typically available 24/7 to address urgent mold issues that can arise from water damage or flooding. Emergency response teams can quickly assess the situation, contain the mold, and begin the removal process to prevent further damage and health risks. It’s advisable to contact local companies directly to confirm their availability and response times.
Frisco, Texas - Mold Removal Official Helpline
For immediate assistance with water damage emergencies, contact the official Florida helpline. Get connected to local services and emergency response teams.
Helpline Numbers:
Places similar to Frisco
Nestled in the heart of Texas, Nocona is a charming small town that beautifully encapsulates the spirit of the Lone Star State. With its rich histo…
Nestled in the heart of the Dallas-Fort Worth metroplex, Bedford, Texas, is a vibrant city that beautifully blends suburban charm with urban conven…
Welcome to Military Parkway, a vibrant area in Texas that offers a unique blend of rich history, community spirit, and modern amenities. Nestled wi…
Nestled in the heart of Texas, Hico is a charming small town that captures the essence of Southern hospitality and American spirit. Known as the &#…
Nestled in the heart of Texas, Venus is a charming small town that embodies the spirit of Southern hospitality and community. With its close-knit a…
Nestled in the heart of North Texas, Van Alstyne is a charming small town that beautifully blends rural charm with the conveniences of modern livin…
No results available
Reset